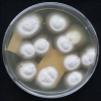

Presentamos el caso de una mujer de 52 años con lesiones escamosas asintomáticas en muslos, aparecidas 3 años antes, que habían sido tratadas con valerato de betametasona durante 2 años, sin notar mejoría. Desde un año antes de consultar a nuestro servicio estaba en tratamiento con metotrexato oral (12,5mg/semana) por diagnóstico de psoriasis pustulosa. Tenía antecedentes personales de hipertensión arterial y asma en tratamiento con losartán, salbutamol y bromuro de ipratropio.
Al examen físico se observaron en abdomen, región lumbar, glúteos, caderas y muslos placas eritematoescamosas con numerosas pústulas (figs. 1 y 2). Además, presentaba descamación y maceración en espacios interdigitales de los pies, onicolisis y paquioniquia en la uña del primer dedo del pie izquierdo. Se realizó examen directo de las pústulas, que mostró la presencia de hifas hialinas ramificadas compatibles con dermatofitos, y cultivo para hongos, del que se obtuvo crecimiento de colonias blancas, felposas, con reverso café, características de Trichophyton rubrum (fig. 3). En la biopsia de piel se observaron abscesos córneos en la epidermis, numerosas hifas y levaduras (fig. 4). Con estos hallazgos se confirmó el diagnóstico de tiña incógnita diseminada y se inició tratamiento con itraconazol oral a dosis de 400mg al día, en 3 pulsos mensuales de 7 días de duración cada uno, y ciclopiroxolamina crema al 1% 2 veces al día, con resolución de las lesiones.
Las complicaciones por el uso de corticoides se han reportado desde su introducción en la terapéutica dermatológica6. A partir de 1968 se empezó a informar sobre casos de tiña incógnita en todo el mundo, pero aún se desconoce su frecuencia. En los reportes y series de casos de tiñas localizadas prevalece el antecedente de aplicación de un corticoide tópico, generalmente fluorado, por un diagnóstico previo equivocado o automedicación7,13–15. Por otra parte, el uso de tacrolimus y pimecrolimus tópico10,12 y los tratamientos sistémicos con ciclofosfamida, ciclosporina, azatioprina y metotrexato se han relacionado con tiñas diseminadas1,3. Cualquiera de estos agentes inmunosupresores enmascara la presentación clínica de la tiña y pueden pasar años antes de que sea diagnosticada correctamente.
La semejanza clínica entre tiña incógnita y psoriasis pustulosa ha sido descrita en niños por Serarslan11 y Kawakami et al.8, y probablemente tiene relación con la capacidad de T. rubrum de invadir los folículos pilosos5,7,15, estimular la síntesis de interleucina 8 a partir de los queratinocitos humanos e inducir quimiotaxis de neutrófilos8. La presencia de pústulas foliculares en pacientes con antecedente de uso continuado de corticoides tópicos podría ser un hallazgo semiológico útil para orientar la sospecha de tiña incógnita, especialmente facial1,7.
En el caso que se presenta, el compromiso de la región glútea y de los muslos permite suponer que el foco de origen de la tiña sería la región inguinal o las uñas de los pies, dos de los principales sitios mencionados como reservorios en otros estudios1,14. Durante los últimos años se han descrito casos por T.rubrum var. raubitschekii como agente etiológico con predilección por el área crural y extensión a los glúteos4.
El tratamiento comienza con la suspensión del medicamento inmunosupresor. Una vez confirmado el diagnóstico se recomienda iniciar la terapia sistémica con antimicóticos orales ante la dificultad para delimitar las lesiones9 y el compromiso de los folículos pilosos15. Los antimicóticos con mejor respuesta terapéutica en casos de tiñas diseminadas son la terbinafina y el itraconazol, probablemente por su actividad fungicida y capacidad de acumulación en la epidermis1,2. Nuestra paciente recibió 3 pulsos mensuales de itraconazol a dosis de 400mg/día durante 7 días, teniendo en cuenta las uñas como posible foco de la infección, sin eventos adversos, resolución de las lesiones e hiperpigmentación residual después del tercer mes de tratamiento.
En conclusión, el diagnóstico de tiña incógnita debe plantearse en los pacientes inmunocompetentes con dermatosis de presentación atípica previamente tratados con corticoides tópicos o inmunosupresores sistémicos, y en pacientes inmunosuprimidos con dermatosis extensas, principalmente si son de aspecto pustuloso, eccematoso o psoriasiforme, que no responden al tratamiento médico.
A la Dra. Zulma Alvarado, micóloga del Centro Dermatológico Federico Lleras Acosta E.S.E., por su apoyo en el diagnóstico micológico y la toma de las fotografías del cultivo.